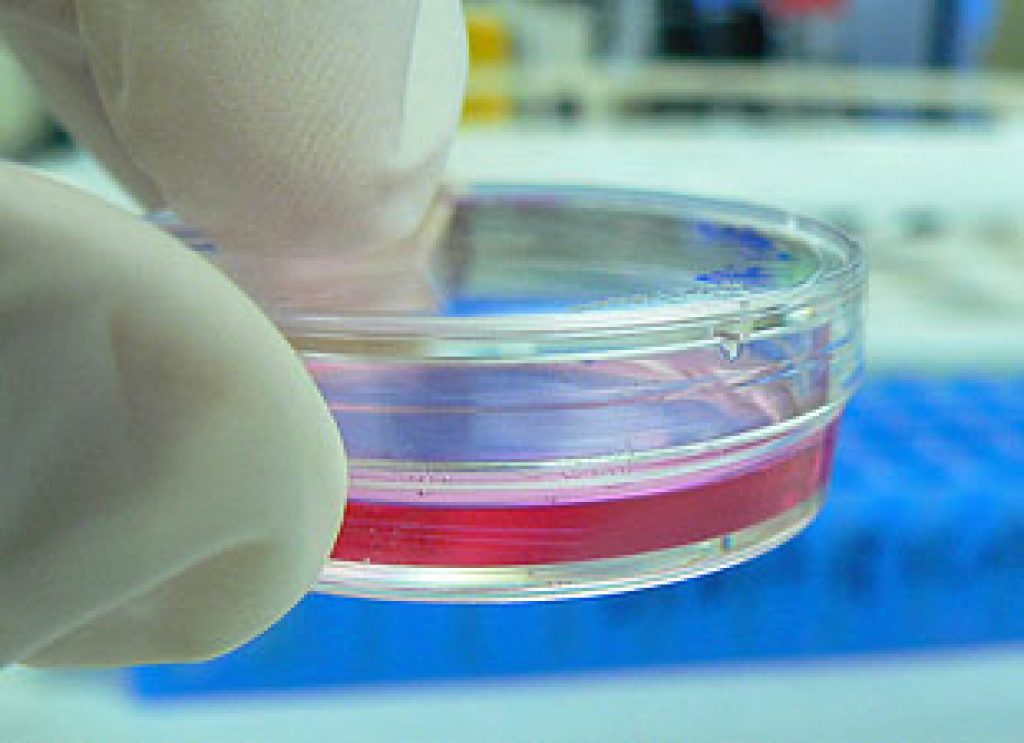

AsianScientist (Jun. 3, 2013) – “There is a healthy pipeline of cell therapies coming from Asia, making it attractive to a contract manufacturing organization (CMO),” said Mr. Kim Raineri, Business Director at Lonza Bioscience Singapore.
Lonza is one of the largest contract manufacturers of biologics in the world and is a global leader in cell therapy manufacturing.
Mr. Raineri was speaking at the Young Investigator’s Symposium on Friday, which was held at the A*STAR Biopolis research complex and organized by the Singapore Stem Cell Society to help young scientists develop networks and establish collaborations with their peers.
The global cell therapy market is growing, he said, with more and more cell therapy products becoming commercially available, such as Carticel (used to repair cartilage injuries) from Genzyme, Provenge (therapeutic cancer vaccine for prostate cancer) from Dendron, and Dermagraft (treatment of diabetic foot ulcers) from Shire Pharmaceuticals.
“This is very significant; it shows we are starting to gain some momentum in the industry. We are starting to see some products get commercialized… We are starting to see some diversification in the types of products that are being approved,” he said.
While the majority of industry-sponsored clinical trials are in the United States, Mr. Raineri said that more than ten percent of the clinical trials were taking place in Asia, for indications that range from cancer to musculoskeletal diseases, non-healing wounds, and cardiac diseases.
He highlighted that cell therapy transactions in the sector with pharmaceutical companies (with other start-up/biotechnology companies and regenerative medicine research institutes) exceeded over a billion dollars last year, emphasizing the financial interest from pharmaceutical companies to drive this industry.
Lonza in the region
Almost a quarter of Lonza’s contract manufacturing clients are based in Asia, said Raineri, and regulatory enforcement is key to the company’s business strategy in the region.
“We maintain a high regulatory and high quality standard. These are global standards and global policies that we have, and that can’t necessarily change from country to country. We maintain one quality standard and that tends to be most compatible with the Federal Drug Agency and European Medical Agency’s regulatory paradigm,” he said, explaining why it is disadvantageous for Lonza to enter countries like China and India, where regulations are weak or unclear.
Factors that determine a CMO’s entry into a country include the ability to obtain reimbursement of cell therapies, market potential, and product development occurring in the country, he said. Rainier stated that reimbursement is in place in Japan but not in the other countries, although some are looking into that. With regards to market potential, defined by the number of potential patients divided by the willingness to participate in cell therapy clinical trials, he said that Singapore and ASEAN are collectively large, but one has to consider individual countries because each country has their unique characteristics. In terms of product development, Rainier said that Japan and South Korea are clear forerunners, with about 9 and 18 ongoing cell therapy clinical trials respectively.
“From a high level view of analysis, Japan and South Korea – from a CMO’s perspective – rise to the top, in areas where we see opportunities and where we see markets are most developed, from a cell therapy industry perspective,” he said.
He went on to elaborate on the pros of doing business in Japan, such as ready embracement of advanced technologies, robust quality oriented culture, people with high earning power who can afford these expensive therapies, and the knock-on effect of extensive research conducted on induced pluripotent stem cells (iPSCs). The cons, however, include complex regulatory processes and nationalistic tendencies, leading to the preference of not out-sourcing CMO activities.
In the case of Korea, Rainier said the country was known for its clear regulatory process and intensive research focus on cell therapy. However, he said that venture capital funding was limited in Korea, and that Koreans were also nationalistic, preferring their CMOs to be located in the country.
Hurdles to cell therapy market development in Asia
Mr. Raineri explained that there were some obstacles to cell therapy market development in Asia, which include the lack of a harmonized regulatory framework, poor funding for translating bench-to-bedside research, issues of reimbursement from governments and health insurance companies, and intellectual property disputes.
He encouraged the young investigators at the seminar to focus on product characterization and the cost of goods, which he believes will help to accelerate the acceptance of cell therapies globally.
“The product is the process when we talk about cell therapy… Characterizing the product, developing good assays, and being able to show how changes in the process and changes in the product equate to clinical efficacy, are going to be very important.
“It is not going to help anybody if it costs hundreds of thousands of dollars to produce one dose. That dose is never going to be produced, and that dose is never going to help anybody.”
——
Copyright: Asian Scientist Magazine; Photo: kaibara87/Flickr/CC.
Disclaimer: This article does not necessarily reflect the views of AsianScientist or its staff.












